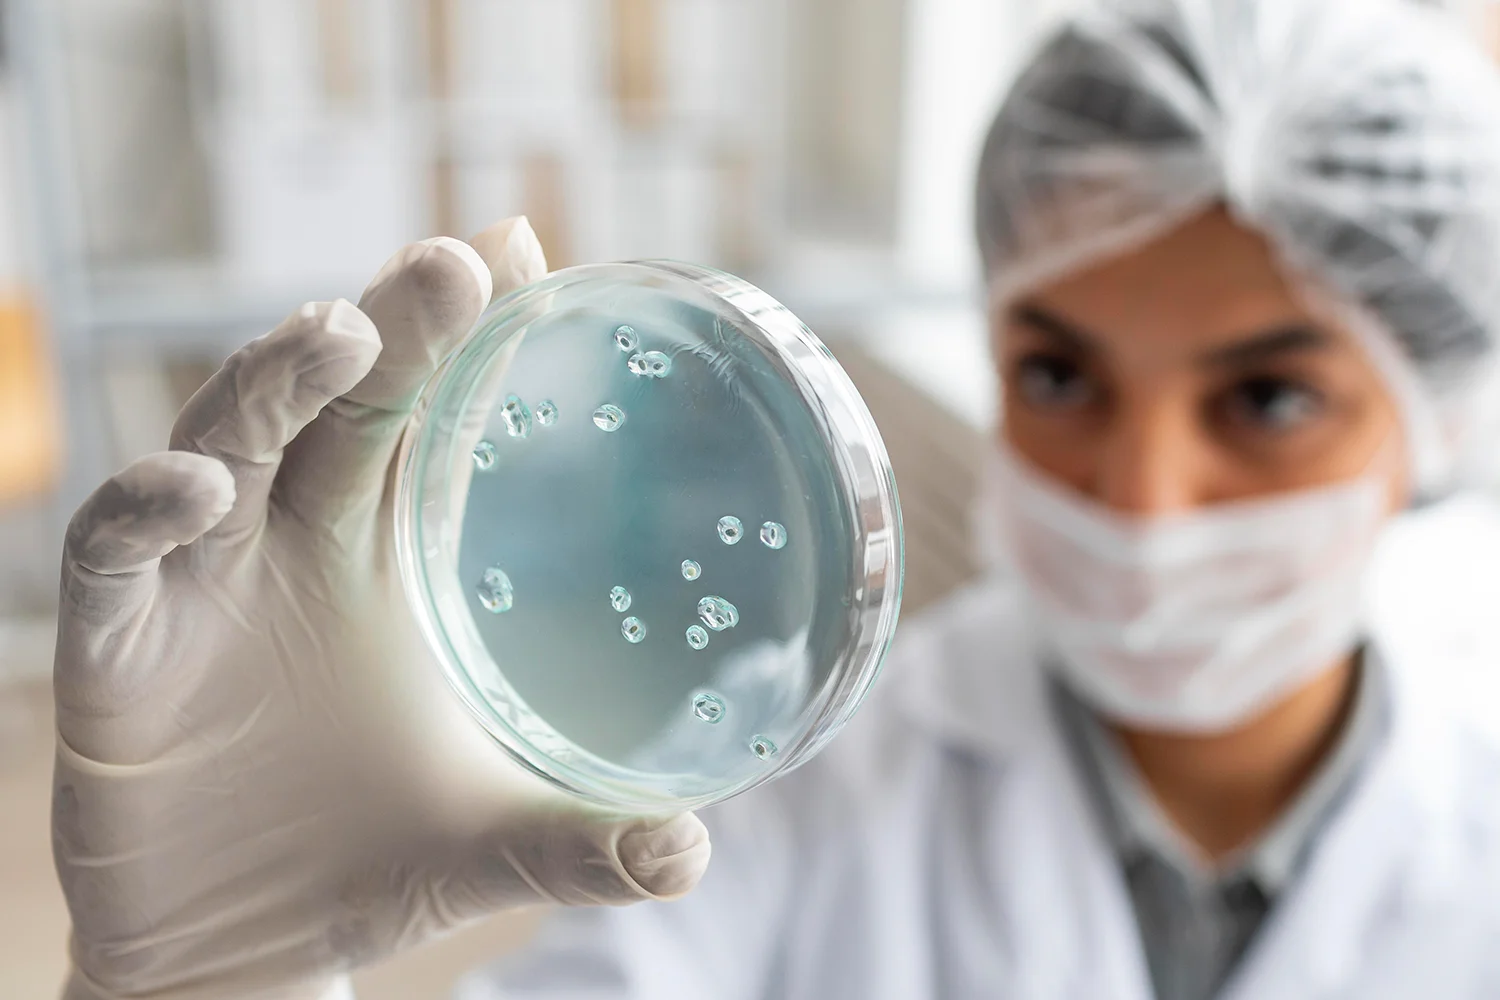

La salmonelosis es una de las infecciones intestinales más frecuentes, especialmente en épocas de calor, cuando aumentan las intoxicaciones alimentarias. Muchas personas la identifican simplemente como “una gastroenteritis por comida en mal estado”, pero detrás de ese término hay una bacteria concreta, formas de transmisión bien definidas y situaciones en las que puede complicarse. Entender cómo se produce la infección por salmonella, cuáles son sus síntomas y cuándo es necesario acudir al médico resulta fundamental para actuar con rapidez y evitar riesgos innecesarios.
La bacteria responsable pertenece al género Salmonella y se transmite principalmente a través de alimentos contaminados o por contacto con personas o superficies infectadas. En la mayoría de los casos provoca un cuadro digestivo agudo que se resuelve en pocos días, pero en determinados grupos de población puede generar complicaciones que requieren tratamiento específico y seguimiento clínico.
Aunque muchas infecciones cursan de forma leve, la salmonelosis no debe banalizarse. Una correcta manipulación de los alimentos, una adecuada conservación y el lavado de manos siguen siendo las medidas más eficaces para prevenirla. Cuando aparece, la hidratación y la vigilancia de los síntomas son claves para una evolución favorable.
Qué es la salmonelosis y cómo se produce la infección
La salmonelosis es una infección causada por la bacteria Salmonella, que afecta principalmente al aparato digestivo. Tras la ingestión de alimentos o agua contaminados, la bacteria llega al intestino, donde invade la mucosa intestinal y desencadena una respuesta inflamatoria. Esa inflamación es la responsable de los síntomas digestivos característicos.
El periodo de incubación suele ser corto, generalmente entre seis y setenta y dos horas después de la exposición. Esto significa que los síntomas pueden aparecer pocas horas después de haber consumido el alimento contaminado. La rapidez de inicio es un dato orientativo en la historia clínica, especialmente cuando varias personas que han compartido comida desarrollan síntomas similares.
No todas las personas expuestas desarrollan la infección con la misma intensidad. La cantidad de bacterias ingeridas, el estado del sistema inmunitario y la edad influyen en la gravedad del cuadro. En adultos sanos suele tratarse de un proceso autolimitado, mientras que en niños pequeños, personas mayores o pacientes con enfermedades crónicas el riesgo de complicaciones aumenta.
Cómo se contagia la salmonelosis y qué alimentos implican mayor riesgo
La vía principal de transmisión es la ingestión de alimentos contaminados. Los productos de origen animal mal cocinados o mal conservados son una fuente habitual. Huevos crudos o poco cocinados, carnes insuficientemente hechas, especialmente aves, y productos elaborados con estos ingredientes pueden convertirse en vehículo de la bacteria si no se manipulan correctamente.
La contaminación cruzada también desempeña un papel importante. Utilizar los mismos utensilios o superficies para alimentos crudos y cocinados sin una limpieza adecuada facilita la transmisión. Además, la salmonella puede encontrarse en el agua contaminada o transmitirse por contacto con personas infectadas que no mantienen una correcta higiene de manos tras ir al baño.
Conviene recordar que no siempre el alimento tiene mal aspecto o mal olor. Muchas veces la contaminación no altera las características visibles del producto. Por eso, las medidas preventivas deben mantenerse incluso cuando los alimentos parecen estar en buen estado.
¿Se transmite de persona a persona?
Aunque la transmisión alimentaria es la más frecuente, la salmonelosis también puede transmitirse de persona a persona por vía fecal-oral. Esto ocurre cuando una persona infectada no realiza un lavado de manos adecuado tras usar el baño y manipula alimentos o superficies que luego entran en contacto con otras personas.
En entornos como guarderías, residencias o núcleos familiares donde conviven varias personas, la higiene resulta especialmente importante. El riesgo aumenta si hay niños pequeños, ya que pueden tener mayor dificultad para mantener una higiene adecuada y mayor susceptibilidad a la infección.